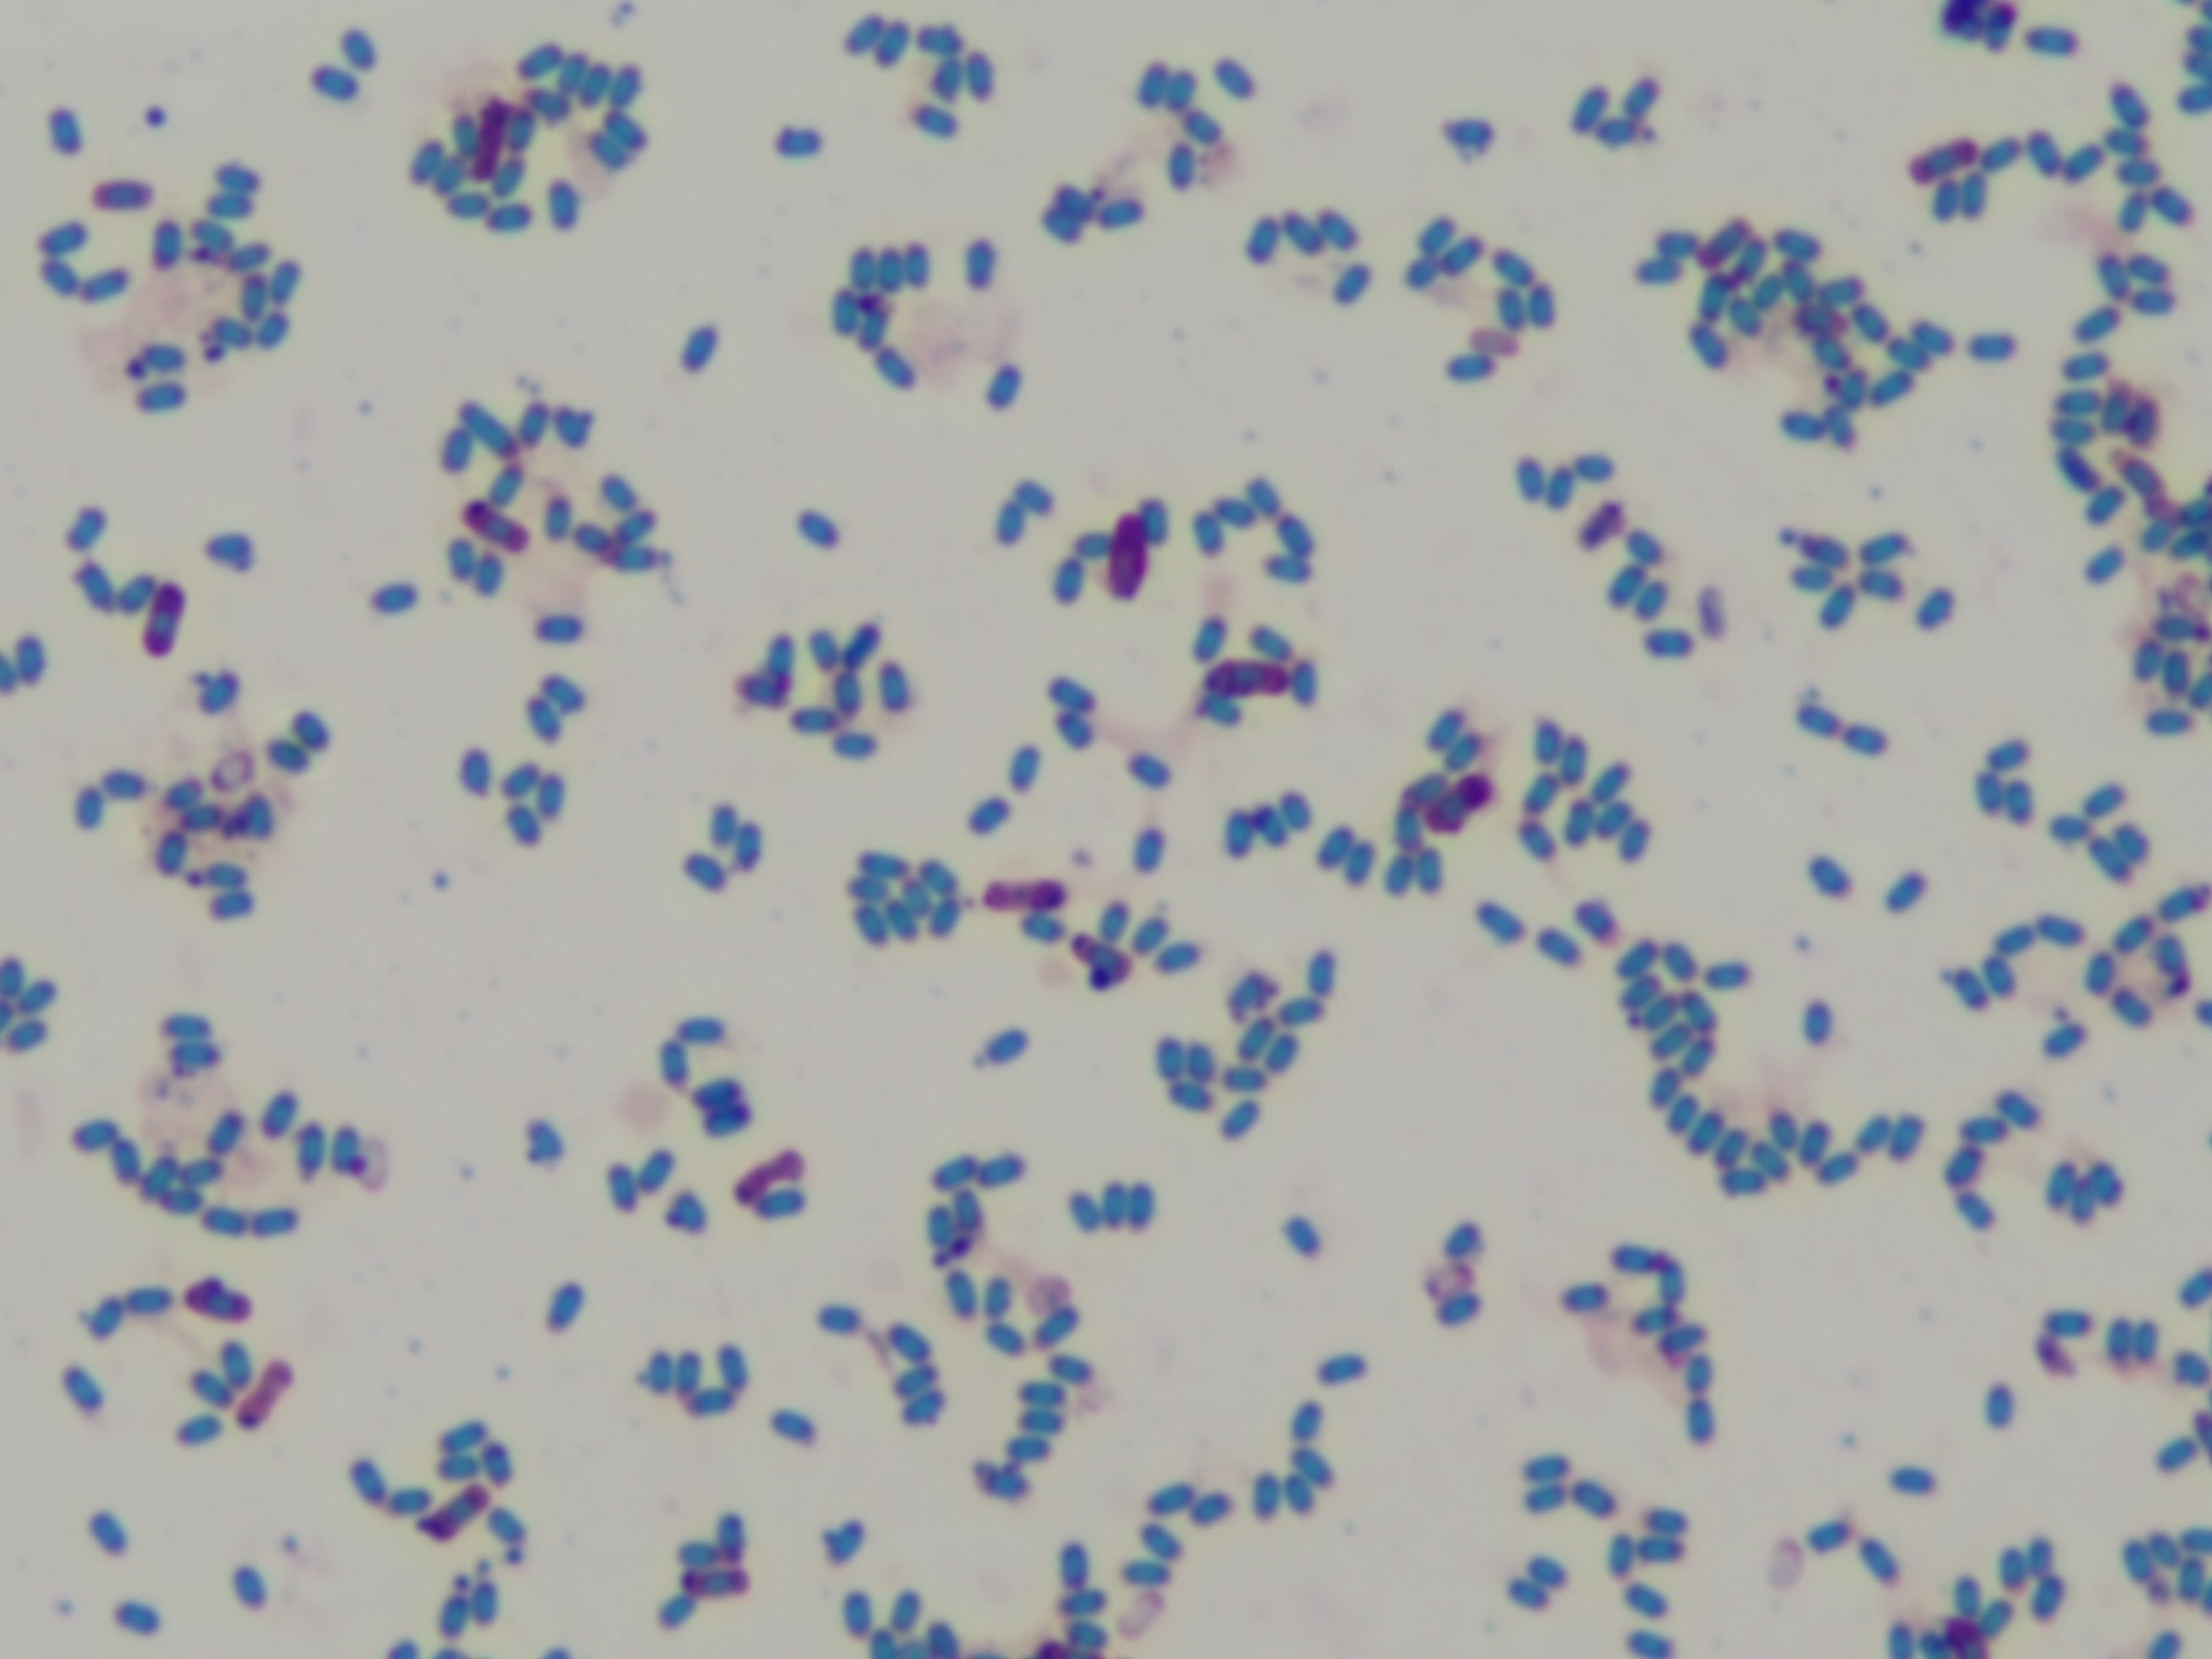

Ingredients Categories
Finished Products
Finished Food Categories
- Bakery
- Beverages / Juices
- Cereal and grain products
- Confectionery
- Cooking Fats & Oils
- Dairy
- Egg products
- Fruits & Vegetables
- Infant & Baby food
- Meat, Poultry & Fish
- Nuts & Seeds products
- Other Finished Food Categories
- Pet Food
- Plant-based foods
- Prepared foods
- Sauces & Seasonings
- Sweet & Savoury Spreads
Health & Wellness Areas
Delivery Formats
Operations & Services
- 3D printing
- Analysis/ Testing
- Auditing & certifications
- Blending & mixing
- Bottling
- Certification
- Clinical Trials
- Co-packing
- Coating
- Consulting
- Contract manufacturing
- Drying
- Electrospinning
- Encapsulating
- Enzymatic processing
- Extracting
- Extrusion
- Fat structuring
- Fermentation
- Filling
- Flavour development
- Freeze Drying
- Granulating/ grinding/ milling / mixing
- High pressure processing
- Labelling
- Other Operations & Services
- Packaging
- Packet filling
- Pasturising
- Quality assurance
- Saccharification
- Sheer cell processing
- Spray drying
- Sterilisation
- Storage & Logistics
- Tabletting
- Toasting / roasting
- Ultra-high temperature processing
Bacillus amyloliquefaciens
Product description
Bacillus amyloliquefaciens is a gram-positive, nonpathogenic bacterium belonging to the Bacillus genus.
Applications:
Suppressing plant pathogens through the secretion of antimicrobial compounds.
Improving nutrient availability in the soil via nitrogen fixation and phosphorus solubilization.
Enhancing root tolerance to abiotic stresses like salinity
Read more
Applications:
Suppressing plant pathogens through the secretion of antimicrobial compounds.
Improving nutrient availability in the soil via nitrogen fixation and phosphorus solubilization.
Enhancing root tolerance to abiotic stresses like salinity
Specifications
| Categories | Fungi & Yeasts, Microorganisms & Probiotics, Mushrooms | Microorganisms & ProbioticsOther Microorganisms & Probiotics |
|---|---|
| Supplied from | India |
Bacillus amyloliquefaciens